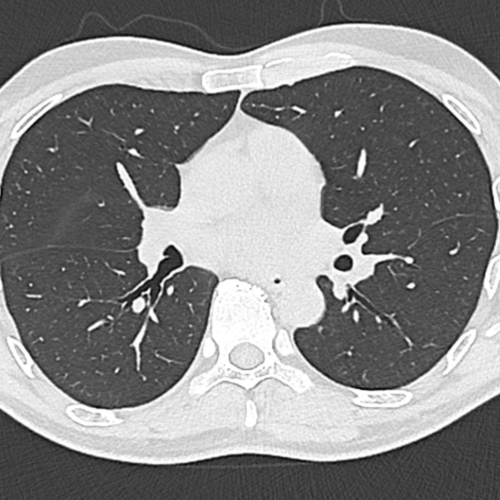
Scanner thoracique pulmonaire IMBM Radiologie Paris

Prendre rendez-vous pour votre scanner thoracique (poumon) à Paris sur Doctolib – Centre de radiologie IMBM Paris
Quand pratique-t-on un scanner TDM pulmonaire ?
Cet examen est réalisé pour analyser le thorax.
Cette technique de visualisation des poumons est réalisée en cas de toux, de suspicion d’infection pulmonaire, de suspicion de cancer des poumons, notamment chez les patients fumeurs. Cela permet également le diagnostic d’embolie pulmonaire (caillot dans les artères pulmonaires)
La TDM thoracique permets également d’analyser les tissus autour du poumon, le médiastin (contient coeur, trachée, gros vaisseaux, oesophage) , la plèvre et les côtes notamment.
Quelles sont les précautions à prendre pour un scanner thoracique au centre IMBM à Paris ?
Lors de la réalisation de votre tomodensitométrie pulmonaire au centre IMBM à Paris, dans le 18ème, vous serez guidé par le manipulateur en radiologie. Il y a peu de contre indication à cet examen. Dans certains cas, une injection de produit de contraste iodé peut être nécessaire. Cela permet de mieux voir les gros vaisseaux, le cœur et le médiastin. Le manipulateur en radiologie vous posera une voie veineuse par laquelle sera injecté le produit de contraste. L’injection est un acte très courant, habituellement très bien toléré.
Comment se déroule un scanner des poumons au centre IMBM Paris ?
Le TDM pulmonaire dure environ 10 minutes. Le manipulateur vous guidera . Il sera nécessaire de rester strictement immobile. Vous serez allongé sur une table d’examen qui se déplace dans l’anneau.Une fois l’examen terminé, les clichés et un compte-rendu vous sont remis par le radiologue (temps d’attente : entre 30 et 45 minutes).
Si vous souhaitez quitter le cabinet uniquement avec les clichés, vous pourrez récupérer le compte rendu sur Internet, directement sur notre site, disponible à partir de 21h.
Quels sont les résultats possibles d’un scanner thoracique ?
Cet examen ( TDM thoracique ) permets de diagnostiquer:
- des nodules qui font suspecter un cancer des poumons.
- une pneumopathie ou pneumonie (infection des poumons)
- une bronchite (inflammation des bronches)
- une dilatation des bronches et bronchocèles ( infection dans les bronches)
- de l’emphysème (destruction du parenchyme pulmonaire par le tabac)
- une fibrose pulmonaire (épaississement fibreux du poumon)
- une pleurésie (épanchement de liquide dans la plèvre)
- un pneumothorax (décollement gazeux de la plèvre)
- Une embolie pulmonaire (caillot des artères pulmonaires)
- un anévrysme de l’aorte thoracique (dilatation de l’aorte thoracique)
- des adénopathies médiastinales (ganglions anormaux du médiastin)
- des fractures costales en cas de traumatisme
- des fractures vertébrales
- des lésions osseuses vertébrales
Quel est le prix d’ un scanner thoracique au centre IMBM Paris ?
Si vous souhaitez plus de précisions sur les tarifs d’un scanner pulmonaire , vous pouvez joindre le secrétariat au 01.42.29.56.06.
Nous réalisons le tiers payant sur la part sécurité sociale ce qui limite l’avance des frais.
Le centre d’imagerie est conventionné avec option OPTAM afin d’assurer un remboursement satisfaisant par les mutuelles. Nous accueillons les patients CMU, C2S, AME, ALD, ACS et les 100%. Le centre est accessible aux brancards et aux fauteuils roulants, permettant un accès des patients hospitalisés en clinique, en maison de retraite (EHPAD), ou à l’hôpital.
Prendre rendez-vous pour votre scanner des poumons à Paris
La centre d’imagerie d IMBM (Imagerie Médicale Batignolles Montmartre) se situe dans le 18ème arrondissement, à deux pas du 17ème et du 9ème arrondissement. Il est accessible également depuis Saint-Denis, Saint-Ouen, Colombes , Asnières, Gennevilliers . Vous pouvez prendre votre rendez-vous pour votre scanner thoracique sur Doctolib. Vous pouvez également nous appeler au 01 42 29 56 06.
Retrouvez l’article du Raphaël Benchimol à propos du scanner thoracique sur le site Doctissimo.